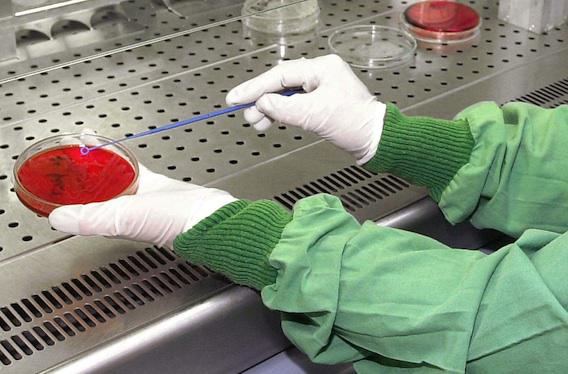

Plaies cutanées bénignes
Corse : quinze enfants infectés par le staphylocoque doré
Une quinzaine d'enfants et adolescents ont été contaminés pas le staphylocoque doré en Haute-Corse. La transmission semble s'être déroulée lors d'une fête début août.
- Par Anne-Laure Lebrun
- Commenting
- JENS MEYER/AP/SIPA
En Haute-Corse, dans la région de Vivario, une quinzaine d’enfants ont été infectés par le staphylocoque doré. Ils ont présenté des plaies cutanées bénignes comme des abcès, des furoncles, des folliculites ou des impétigos aux jambes et aux coudes.
« Les personnes concernées ont pour seul lien possible de contamination des jeux d’eau à partir d’une structure gonflable installée pour la fête du 1er août à Vivario, structure qui n’est pas la cause de l’infection mais qui a constitué un facteur facilitateur pour la transmission interhumaine (contacts rapprochés) », indique Jean-Jacques Coiplet, directeur général de l’Agence régionale de santé (ARS) de Corse.
Rarement sévère
Tous les enfants et adolescents, âgés de 5 à 12 ans selon Corse Matin, ont été pris en charge et ont reçu un traitement antibiotique et une pommade. L’ARS appelle toutes les personnes ayant participé à la fête à Vivario début août et qui présentent les signes cutanés de l’infection à se rendre chez un médecin.
En parallèle, des investigations ont été engagées par la Direction générale de la santé (DGS) et l’Institut de veille sanitaire (InVS) afin d’évaluer les risques et identifier le foyer infectieux. « Tous les tests effectués jusqu'à présent, notamment au niveau de l'eau, se sont avérés négatifs », a révélé Hyacinthe Raffiani, maire du petit village, interrogé par nos confrères.
Par ailleurs, l’ARS se veut rassurante et précise que les infections à staphylocoque doré sont très rarement responsables d’infections sévères.

























